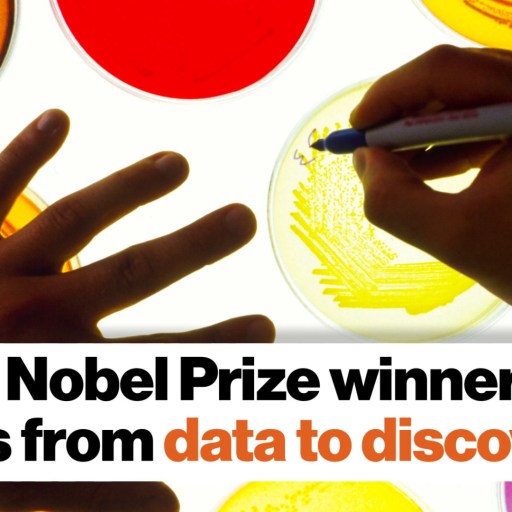

This content is locked. Please login or become a member.
SUSAN HOCKFIELD: Take them away from their loved ones, And cancer has been, for all of human history, among the most insidious. The best way to address cancer or any disease is to prevent it. Vaccines are enormously important in preventing disease. It's much harder to fix a disease once you get it than it is to prevent you from getting the disease. So vaccines are very important. For cancer, we've determined a number of carcinogens things that will drive the development of cancer in some people. And so prevention is sometimes avoidance. Stopping smoking. In the United States, smoking cessation has resulted finally in a reduction of deaths from cancer.
Staying away from asbestos, wearing sunscreen when you go in the sun. But even if all of us were to have all the vaccines that are prescribed and exercise all of the preventions, cancer would still be with us. Cancer is an aberrant function of a normal cell, where the regulators of that cell's dividing are broken and the cell starts to divide without regulation. Left to its own devices, that dividing without regulation will overcome the entire body. And that is how cancer kills you. Now cancer is easier to treat if you can stop it where it starts. Cancer usually starts as a very small group of aberrantly dividing cells. With time, those cells break loose from the original site and will metastasize to other sites and set up new cancers there. And these cells are very mutagenic.
That means their DNA changes very rapidly. Most cancer cells have lost the ability to regulate their DNA mutation. And it is a biological challenge to control cancer once it has progressed to a certain level. So if you can't prevent cancer, the next best strategy is early diagnosis. Because if you can stop it when it's only a few hundred cells, before it's escaped its original location and gone to another location, there's a very high probability of cure. We have some very good diagnostic tests that have reduced the rates of death from colon cancer and breast cancer. Quite remarkable advances on those two cancers and some others. But even those technologies don't detect cancer when they're small enough and don't detect it reliably enough. There is a possibility I say a very real possibility that using a biology-engineering convergence based on nanotechnology, we may have a way to diagnose cancers much earlier than we can today.
One example that I give in the book is from the laboratory of Sangeeta Bhatia. And she has devised a young approach that she calls synthetic biomarkers. Biomarkers are things that measure something that's going on biologically in the body. Synthetic means that her biomarkers are something that she has synthesized, and she's synthesized them using nanotechnology. So one of the remarkable things about living things, about humans, all animals and plants, is there's a lot of specificity. There's a specificity in different tissues. There's a specificity in different diseases. So for example, our skin looks different from our liver. It looks different from our brain. And it's because the cells that make up each of those tissues expresses a different set of genes and a different set of proteins. It's absolutely remarkable, and one of the most interesting pursuits in biology is understanding that kind of gene regulation. It is magical. It's fantastic.
We understand a little bit about it, but there's much more to be learned. Suffice it to say that in cancer, there's a certain set of genes that get turned on and those genes express a certain set of proteins. For a cancer cell to grow and spread, it has to get rid of the things that would normally inhibit spreading. So our normal cells don't migrate around. They don't even grow beyond the bounds of where they're supposed to be. But cancer cells make proteins called enzymes, and enzymes are molecular scissors that cut up the things that stand in the way of cancer growing and spreading. And these enzymes are relatively specific for cancer. So Sangeeta Bhatia has thought, well, if we could detect the expression of those enzymes, we would have a way of detecting cancer. And she does it with a very, very clever device.
She starts with a nanoparticle, and she decorates the nanoparticle with a short stretch of a protein that contains she has synthesized it to contain the site that a cancer enzyme will cut. So if you don't have cancer and you're injected with these nanoparticles, the nanoparticles continue to be whole and eventually will go the way of all things that we don't need in the body. But if you do have cancer, the cancer enzymes will clip these little proteins off and produce very, very tiny peptides, short stretches of protein. She's made those short stretches of proteins small enough that the kidney the kidney is the organ that filters our blood and produces urine but in the urine are no real proteins. The kidney's filter only allows very small things to pass. So these clipped off bits of protein, these little peptides, get filtered from the kidney into the urine.
And in her system, you do a urine test to see whether those little peptides are present. If you don't have they're not going to be there because you don't have the enzyme that cuts them off. If you do have cancer, you'll detect these peptides in the urine. Everyone knows about over-the-counter pregnancy tests, peeing on a stick. The same principle, that there are proteins that appeared in the urine if you're pregnant because these are very, very small proteins that get filtered by the kidney into the urine. They're cheap. So Sangeeta Bhatia's technology has a possibility of giving us inexpensive non-invasive tests so we can follow the progress of a disease, you can determine whether you have a disease or not.
She has a company called Glympse Bio that's Working on this for the marketplace. And I'm an enthusiast. I think this is a marvelous set of ideas. I wouldn't be surprised if in five or 10 years part of your annual physical exam would include the urine sample, which you give anyway, but monitoring that urine sample for the appearance of the signals of any number of diseases that if you can detect early, you can cure them and not simply contain them.